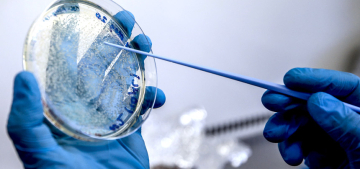

Almanya daha fazla Kovid-19 testi yapılacak

Almanya Sağlık Bakanı Jens Spahn, "Enfeksiyon zincirini önceden tespit etmek ve kırmak için daha fazla test yapılmasını sağlayacağız." dedi. Almanya'da yeni tip koronavirüs (Kovid-19) salgınıyla mücadele kapsamında Kovid-19 test sayısının arttırılacağı bildirildi. Sağlık Bakanı Jens Spahn, bugün düzenlenen kabine toplantısında yaptığı konuşmada, salgının seyrini daha iyi izlemek, risk altında bulunanları daha iyi korumak ve sağlık sistemini iyileştirmek amacıyla hazırlanan yasa tasarısının kabul edildiğini söyledi. Spahn, özellikle huzurevi ve bakımevlerinde bulunanlara daha fazla test yapılacağını kaydederek, "Enfeksiyon zincirini önceden tespit etmek ve kırmak için daha fazla test yapılmasını sağlayacağız." ifadesini kullandı. Yaşlı insanların Kovid-19'dan daha fazla etkilendiğine işaret eden Spahn, "Koronavirüsten hayatını kaybedenler arasında çok üzücü, kısmen çok acı örnekler var." dedi.
NEGATİF ÇIKANLAR DA KAYIT ALTINA ALINACAKSpahn, Kovid-19 testi negatif çıkanların da bundan sonra kayıt altına alınacağını belirterek, böylelikle salgının seyrini daha iyi takip edeceklerini ifade etti. Alman Bakan ayrıca, kabul edilen yasa tasarısı kapsamında federal hükümetin gelecek kış dönemi için 4,5 milyon kutu grip aşısı satın alacağını ve salgın sırasında yoğun çalışan sağlık personelinin maddi olarak destekleneceğini kaydetti. Almanya'da haftada 350 bin Kovid-19 testi yapıldığı bildirilmiş, ancak test kapasitesinin haftada 750 bin olduğu ifade edilmişti.
Haber: Erbil Başay – (Almanya Bülteni) – Berlin
Kaynak: (AA)